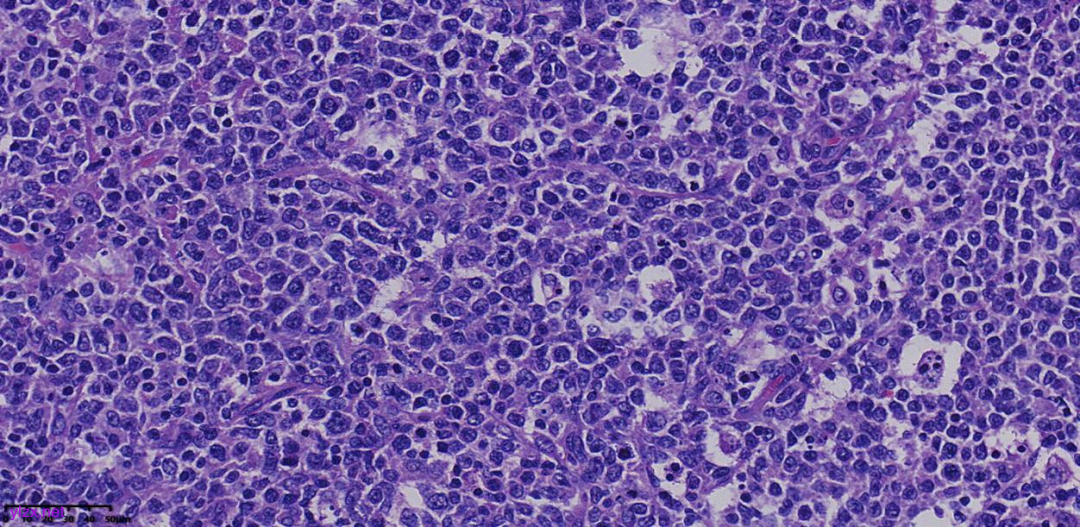
图片

【衡道丨病例】病理诊断——滤泡性大B细胞淋巴瘤
时间:2025-04-30 12:09:02 热度:37.1℃ 作者:网络
病史
男性,79岁,全身多发淋巴结肿大伴无规律发热、盗汗,体重减轻B症状,取颈部淋巴结活检。
大体所见
淋巴结1枚,直径1.8cm,切面灰白质嫩。
镜下所见

图1:低倍镜下淋巴结内见大小不等的结节状结构,是一个以结节性生长方式为主的淋巴组织增生性病变,局部淋巴结被膜增厚。

图2:结节大小不等,排列拥挤,部分结节内可见星空现象。

图3:结节似淋巴滤泡生发中心,但周围未见明显套区、边缘区存在,未见明区、暗区正常淋巴结极向,提示为肿瘤性的生发中心。

图4:结节内瘤细胞核大,呈空泡状,核仁明显,似中心母细胞,其间散在巨噬细胞,未见明确中心细胞。
图5:高倍镜显示结节内中心母细胞样细胞增生,弥漫分布,核分裂象活跃,可见星空现象,表明肿瘤增殖活性高。
免疫组化

CD3

CD20

CD23
图6:免疫组化显示结节内瘤细胞CD3阴性,CD20弥漫阳性,结节外也有CD20阳性的细胞分布,CD23显示结节内残存且破坏的FDC网,说明肿瘤为B细胞来源,且位于生发中心内。

BCL6

BCL2

MUM1
图7:免疫组化显示BCL6阳性,表明肿瘤细胞为生发中心起源B淋巴细胞,BCL2阴性,MUM1散在阳性。
病理诊断
滤泡性大B细胞淋巴瘤。
病理诊断要点
滤泡性淋巴瘤是一种由生发中心B细胞组成的成熟B细胞淋巴瘤,至少部分区域呈结节状滤泡结构,由中心细胞和中心母细胞组成;
根据中心母细胞的数量将滤泡性淋巴瘤分为3级:
1级(0-5个中心母细胞/HPF);
2级(6-15个中心母细胞/HPF);
3A级(>15个中心母细胞/HPF,但仍可见中心细胞);
3B级(>15个中心母细胞/HPF,中心母细胞呈实性片状分布)。
第5版WHO在滤泡性淋巴瘤的亚型有新的改动:
1.经典型滤泡性淋巴瘤(相当于滤泡性淋巴瘤1级、2级、3A级);
2.滤泡性大B细胞淋巴瘤(相当于滤泡性淋巴瘤3B级);
3.滤泡性淋巴瘤伴罕见特征;
形态学特征:
低倍镜下病变呈结节状分布由紧密排列的膨胀性淋巴滤泡构成,部分滤泡不规则,套区消失或变薄,生发中心内见中心母细胞样细胞和/或中心细胞样细胞,星空现象通常消失;
免疫组化:
瘤细胞通常CD10、BCL6,BCL2(级别高时可阴性)阳性,CD21、CD23显示滤泡树突网存在,但通常为增生、紊乱的滤泡树突网;
BCL2 基因有助于滤泡性淋巴瘤的诊断。
病理诊断体会
第五版WHO中滤泡性淋巴瘤的诊断用语有改动,我们应该紧跟时代的步伐进行诊断;
把此类既往滤泡性淋巴瘤3B级的病例诊断为滤泡性大B细胞淋巴瘤;
在诊断滤泡性大B细胞淋巴瘤时,我们需注意:
1.仔细寻找有无肿瘤细胞弥漫生长区(用CD21、CD23进行标记),如果部分区域FDC网消失,肿瘤细胞弥漫性生长,需要诊断为弥漫性大B细胞淋巴瘤合并滤泡性淋巴瘤;
2.需要与伴IRF4重排的大B细胞淋巴瘤进行鉴别,两种形态学几乎一样,但后者免疫组化MUM1强阳性,FISH检测到IRF4基因重排;
3.高级别的滤泡性淋巴瘤BCL2和CD10可丢失表达,BCL6表达多见,提示为生发中心内细胞,BCL2丢失表达后可做FISH检测来证明有BCL2基因的重排,从而支持诊断。

